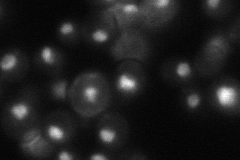
YML127W

View description
Component of the RSC chromatin remodeling complex; DNA-binding protein involved in the synthesis of rRNA and in transcriptional repression and activation of genes regulated by the Target of Rapamycin (TOR) pathway
Localization:
Intensity:
Fold change:
Significance:
-
C’ GFP library in SD

nucleus48.8 -
N' NOP1pr-GFP in SD

nucleus105.546 -
N' TEF2pr-mCherry in SD

nucleus87.6383 -
N' NATIVEpr-GFP in SD
nucleus45.521 -
N' TEF2pr-VC and Cyto-VN in SD

nucleus44.5517 -
C’ GFP library in SD+DTT

nucleus53.61.09No -
C’ GFP library in SD+H2O2

nucleus61.691.26No -
C’ GFP library in Starvation Media

nucleus57.331.17No -
C’ GFP library on the background of Pup2-DaMP

nucleus -
C’ GFP library on the background of CCT mutant

nucleus53.11451.0883No
